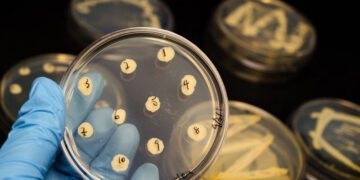
Pharma's Future Frontiers: Predicting the Next Wave of Therapeutic Discoveries

In today’s digital age, the traditional definition of consumer durables has been rewritten. The age-old appliances that once operated in isolation are now becoming ‘smart’. They communicate, learn, and evolve, thanks to the power of the Internet of Things (IoT). This technological shift is ushering in an era where household gadgets are not just functional entities but are interconnected, intelligent devices.
“The symphony of IoT in consumer durables is creating a harmonious household where devices converse, adapt, and optimize.”
Understanding the IoT Paradigm
IoT refers to the connection of devices (other than typical fare such as computers and smartphones) to the internet. When your coffee machine can initiate brewing as your alarm clock buzzes or your refrigerator can order milk when you’re running low, you’ve stepped into the IoT realm.
The Advent of Smart Appliances
From air conditioners that can be controlled using smartphones to washing machines that can diagnose their malfunctions and send alerts, the boundaries of what appliances can achieve are being constantly expanded.
Consumer Benefits
Convenience: The foremost advantage is the sheer convenience. Being able to preheat your oven from your office or monitoring the contents of your fridge from the grocery store saves time and effort.
Energy Efficiency: Smart appliances often optimize energy usage based on patterns and can suggest efficient running schedules or go into energy-saving modes during periods of inactivity.
Customization: These appliances learn user behaviors and patterns over time, allowing them to customize their operations for individual preferences.
The Role of Manufacturers
Embracing IoT is not just about embedding a chip into a device. It requires a holistic approach where manufacturers have to consider security, user interface, and seamless integration with other devices and platforms.
Companies are partnering with tech giants, startups, and even app developers to ensure that their smart appliances offer genuine value and a seamless user experience.
Challenges in the Smart Transition
Security Concerns: As with anything connected to the internet, security remains a paramount concern. The potential for hacking or unauthorized access can have dire consequences.
Cost Implications: Smart appliances are invariably more expensive than their non-smart counterparts. This can deter a section of the population from adopting them.
Complexity: The learning curve associated with adapting to these smart devices can be steep for some, especially the elderly.
Conclusion
The confluence of IoT with consumer durables is shaping the future of households. While the journey of smart durables is still in its nascent stages in India, the potential for growth and the benefits they bring make it a revolution worth watching.